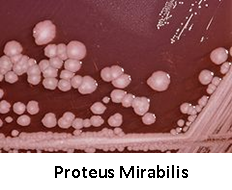

Bentonit Solüsyonunun Bakteri Tutma (Emme) Gücü
Dr. Howard E. Lind tarafından geçmiş yıllarda yürütülen deneysel çalışmalarda Bentonit Solüsyonun Emme (Yüzeye yoğunlaşma ve tutunma yoluyla) gücünün tespit edilmesi amaçlanmıştır, Bu deneysel çalışmalar, çeşitli bakteriler üzerinde uygulanmıştır.
 1. Deneysel çalışma: Hastane enfeksiyonları, idrar yolu enfeksiyonları ve yara enfeksiyonlarında bulunan Enterobacteriaceae familyasının bir türü olan çubuk şeklinde gram negatif bir bakteri türü olan SERRATIA MARCESCENS bakterisi kültüründen bir miktar, hazırlanan bentonit solüsyonuna eklenerek belirli zaman aralıklarında gözlemler ve bakterilerin sayımı yapılmıştır. İki kere uygulanan bu test çalışmasının sonuçlarına aşağıda yer verilmiştir.
1. Deneysel çalışma: Hastane enfeksiyonları, idrar yolu enfeksiyonları ve yara enfeksiyonlarında bulunan Enterobacteriaceae familyasının bir türü olan çubuk şeklinde gram negatif bir bakteri türü olan SERRATIA MARCESCENS bakterisi kültüründen bir miktar, hazırlanan bentonit solüsyonuna eklenerek belirli zaman aralıklarında gözlemler ve bakterilerin sayımı yapılmıştır. İki kere uygulanan bu test çalışmasının sonuçlarına aşağıda yer verilmiştir.
Bu deneysel çalışmanın sonucu olarak, her 30 dakikada bir yapılan bakteri sayısı ölçümlerinde ciddi azalmalar tespit edilmiş, her iki uygulamada da 90 dakika sonunda 24 saat kültürlenmiş SERRATIA MARCESCENS bakteri sayısının, % 25 bentonit konsantrasyonlu solüsyon içerisinde % 85 ile % 99 arasında bir azaltma gözlemlenmiştir. Bu çalışma sonucunda, bentonitin bu bakteriyi öldürmeden, emilim yoluyla uzaklaştırabildiği tespit edilmiştir.
 2. Deneysel çalışma: 1. deneysel çalışmada izlenen metod ile, kendi soyu genel olarak zararsız olan, ancak serotipleri ciddi gıda zehirlenmelerine sebebiyet verebilen, genellikle sıcak kanlı organizmaların (endotermler) alt bağırsaklarında bulunan, çubuk şeklindeki gram negatif bir bakteri türü olan ESCHERICHIA COLI ile her zaman patojen olmamakla beraber, deri enfeksiyonları (örneğin çiban), solunum hastalıkları (örneğin sinüzit), ve gıda zehirlenmelerinde sık görülen ve özellikle de Patojen olan türlerinin dirençli formlarının ortaya çıkması ile birlikte (örneğin MRSA hastalığı) tıp dünyasında ciddi bir sorun olarak görülen gram pozitif bir bakteri türü STAPHYLOCOCCUS AUREUS bakterileri üzerinde bentonitin emme kabiliyetini görmek için deneysel çalışmalar yapılmıştır.
2. Deneysel çalışma: 1. deneysel çalışmada izlenen metod ile, kendi soyu genel olarak zararsız olan, ancak serotipleri ciddi gıda zehirlenmelerine sebebiyet verebilen, genellikle sıcak kanlı organizmaların (endotermler) alt bağırsaklarında bulunan, çubuk şeklindeki gram negatif bir bakteri türü olan ESCHERICHIA COLI ile her zaman patojen olmamakla beraber, deri enfeksiyonları (örneğin çiban), solunum hastalıkları (örneğin sinüzit), ve gıda zehirlenmelerinde sık görülen ve özellikle de Patojen olan türlerinin dirençli formlarının ortaya çıkması ile birlikte (örneğin MRSA hastalığı) tıp dünyasında ciddi bir sorun olarak görülen gram pozitif bir bakteri türü STAPHYLOCOCCUS AUREUS bakterileri üzerinde bentonitin emme kabiliyetini görmek için deneysel çalışmalar yapılmıştır.
4 saat kültürlenmiş (aşırı kümelenmenin önlenmesi için 24 saat yerine uygulandı.) STAPHYLOCOCCUS AUREUS bakterisi üzerinde yapılan 3 uygulamada ise, % 20 ile 30 arasında değişen bentonit içerikli solüsyonlarda, ortalama % 33 başarı elde edilmiştir.
3. Deneysel çalışma: Diğer deneysel çalışmalarda izlenen yola benzer olarak, Çubuk şeklinde, İshale yol açan ve insanlarda tüm Proteus enfeksiyonlarının % 90’una yol açan gram negatif türü bir bakteri olan PROTEUS MIRABILIS ve daha önce her biri üzerinde çalışma yapılmış Proteus mirabilis, Escherichia coli ve Staphylococcus aureus bakterilerinin karışımı üzerinde çalışmalar yapılmıştır.
3. Deneysel çalışma: Diğer deneysel çalışmalarda izlenen yola benzer olarak, Çubuk şeklinde, İshale yol açan ve insanlarda tüm Proteus enfeksiyonlarının % 90’una yol açan gram negatif türü bir bakteri olan PROTEUS MIRABILIS ve daha önce her biri üzerinde çalışma yapılmış Proteus mirabilis, Escherichia coli ve Staphylococcus aureus bakterilerinin karışımı üzerinde çalışmalar yapılmıştır.
Deneysel çalışmanın ilk bölümünde, her 30 dakikada bir yapılan bakteri sayısı ölçümlerinde ciddi azalmalar tespit edilmiş, her iki uygulamada da 120 dakika sonunda 4 saat kültürlenmiş (aşırı kümelenmenin önlenmesi ve bakteri konsantrasyonunun azaltıldığındaki durumu görebilmek için 24 saat yerine uygulandı.) PROTEUS MIRABILIS bakteri sayısının, % 15’i bentonit içeren solüsyon içerisinde % 100 başarı sağlanmıştır.
Yapılan sayım ve gözlemler neticesinde, çalışma daha düşük bakteri konsantrasyonlu solüsyon içinde yapıldığında, % 15 konsantrasyonlu bentonitin selektif emme (tutma) özelliği gösterdiği tespit edilmiştir. Başarı oranları sırasıyla Proteus Mırabılıs için % 95-100, Escherıchıa Colı için % 83-100, Staphylococcus Aureus içinse % 100 olarak tespit edilmiştir.
Deneysel çalışmalar ışığında yapılan değerlendirmelerde, bentonitin düşük konsantrasyonlu bakterilerde üzerinde selektif emme (tutma) özelliği gösterdiği belirtilmiştir. Ancak, bakteri karışımının toplam sayısının 100 binin üstünde olduğu ve bentonit konsantrasyonun aynı kaldığı durumlarda, selektif emme (tutma) özelliğinin az ve hiç olmadığı gözlemlenmiştir. Bentonitin Bakteri karışımlarındaki Selektif emme (tutma) özelliğinin arttırılması için bentonit konsantrasyonunun, tek tip bakterilerde kullanılan konsantrasyonundan daha fazla olması gerektiği sonucuna varılmıştır.
Bu çalışma ile birlikte önemli olan diğer bir sonuç ise, bentonitin istenmeyen bakterilerinin uzaklaştırılmasını sağlarken, istenen bakterileri de uzaklaştırma ihtimali olduğudur. Ancak, uzaklaştırılması istenen ve istenmeyen bakterilerin sayısındaki ciddi bir fark, bu sorunu ortadan kaldıracaktır. Örneğin, normal bir insanda, istenen bakteri sayısı, 100 bin ile 100 milyon arasında değişebilirken, istenmeyen bakterilerin sayısı bu rakamların sadece % 1’i olabilmektedir.
Bu durumu göstermek için, istenen bakteri sayısının 50 milyon, istenmeyenlerin ise 1 milyon olduğu bir durumu değerlendirelim. Fazla miktarda bentonit alımıyla birlikte hem istenen hem de istenmeyen bakterilerin her birinin aynı sayıda mesela 500 bininin emildiğini varsayalım. Bu durumda, istenen bakteri sayısı 49.5 milyon, istenmeyen ise 0.5 milyon olmaktadır. Bu şekilde bile normal bir insan olması gereken ve emildiğinin varsaydığımız 0.5 milyon istenen bakteriyi çok hızlı bir şekilde yeniden oluşturacaktır.
3 deneysel çalışmanın da ingilizce metinlerine aşağıda yer verilmiştir.
Laboratory Experıments On Hydrated Bentonıte
Illustrating the Mechanics of How It Acts as an Aid in Detoxification via the Alimentary Tract. conducted by Dr.Howard E. Lind
Experiment – 1
Purpose: To demonstrate in vitro sorptive ( to condense and hold upon its surface ) powers of an aqueous solution of bentonite. Procedure: One hundred fifty milliliters of the Bentonite preparation were placed in a 250 ml. beaker which contained a plastic coated magnetic agitator. One ml. of a 24 hour broth culture of serratia marcescene was added to the bentonite preparation and the beaker placed on a magnetic agitator. One ml. of a 24 hour broth culture of serratia marcescene was added to the bentonite preparation and the beaker placed on a magnetic stirrer. In order to avoid the heat of the magnetic stirrer the beaker was placed approximately 1/4 inch above the base. After five minutes of stirring, 1 ml. of bentonite suspension was removed for culturing. A brass-coated mesh cylinder containing alkaline pellets was lowered into the bentonite-bacteria mixture and allowed to remain for thirty minutes. The cylinder with its surrounding jell was removed, washed with water, filled with new pellets and again placed in the bentonite-bacteriasolution. This was repeated at 30 minute intervals for 90 minutes. This experiment was repeated several times to show that the phenomenon was genuine and reproducible. Results: The two trials below indicate the quantitative extremes of bacteria population change. These two trials representing the extremes of a series of runs show a minimum reduction of 85% and a maximum reduction of 99 % of the bacteria in 90 minutes. Results indicate that approximately 25% of the bentonite preparation was able to remove 85% to 99% of the organisms. Summary: The results indicated that by the in vitro method it has been possible to demonstrate that the bentonite preparation Vit-Ra-Tox #16 ( et al. ) is able to remove bacteria by sorption. It was definitely established that the bacteria were not inactivated but were removed by sorption.
Experiment – 2
Problem: To demonstrate in vivo sorption powers of a bentonite preparation against two organisms, Escherichia coli ( a gram-negative organism ) and Staphylococcus Aureus ( a gram-positive organism ).Procedure: Essentially the same as in Experiment I, reported above, but modified by using a four-hour culture instead of the 24-hour culture of Experiment I. This was to avoid excessive clumping of the organisms.Results: The above two trials show that the E. coli were reduced 100% and 91% respectively after 60 to 90 minutes using only about 20% of the bentonite preparation. This compares favorably with the removal of the serratia marcescents in Experiment I above. With S. Aureus ( a gram-positive organism ), in Trials 1, 2, 3, it was shown that the numbers of S. Aureus were reduced 21%, 39%, and 40% respectively, or an average of 33%. Results of these trials indicate that 20-30% of the bentonite was able to remove 33% of the organisms.Summary: The research indicated that by the technique employed, it has been possible to confirm the previous conclusion that the bentonite preparation can remove significant numbers of certain gram-negative bacteria, while it appears to be only one-third as effective as to a gram-positive organism, S. Aureus.
Experiment – 3
Purpose: To demonstrate in vitro sorptive powers of a bentonite preparation against A. Proteus mirabilis, a gram-negative organism which can cause diarrhea, and B. its selective sorptive value in a mixture of 3 organisms, namely Proteus mirabilis ( gram-negative ), Escherichia coli ( gram-negative ) and Staphylococcus aureus ( gram-positive ). Procedure: Essentially the same as that used in Experiment I and II above, using the 4-hour culture used in Experiment II instead of the 24-hour one of Experiment I, and lowering the concentration of each organism. Results: In trials #1 and #2, it was shown that the numbers of Proteus mirabilis were reduced 100% after 90 to 120 minutes in the concentration of organisms employed by 15% of the volume of bentonite. In trials #3 and #4 it was indicated that approximately 15% of the bentonite preparation removed from 95-100% of Proteus mirabilis organism, 83-100% of the E. coli organisms and 100% of the S. aureus organism in the concentrations employed. In other words there appeared to be selective sorption when the quantity of organism concentration was much less than the high concentration used in previous tests. Comments: With lower concentrations of mixed organisms there appears to be selective sorption. However, when the population of mixed organisms is over 100,000 and the concentration of bentonite remains the same as when individual organisms were used, there was apparently little or no selective sorption by the technique employed. Thus it may be that selectivity of mixed organisms above 100,000 will require the use of a much larger quantity of bentonite than that used for sorption of single organisms or for sorption of mixed organisms under 100,000 population. While the bentonite is working to remove the undesirable bacteria it could also remove an equal number of desirable bacteria, but when one realizes the large difference in the relative population of the this may not present a problem. In a normal healthy individual the population of desirable bacteria can run from 100,000 to 100,000,000 per cubic centimeter while the undesirable will generally run only 1/10 of one percent to 1% ( .001 to .01 ) of that number. However, when the population of undesirable bacteria gets up to 2% or 3%, the individual may be in real trouble and may perhaps have as, cramps, or serious diarrhea. To illustrate, assume a desirable population of 50,000 organisms with 1% undesirable or 500,000, assuming that the undesirable population increases to 2% or 1,000,000 and by increasing the quantity of bentonite suppose we removed 500,000 of each within 2 hours, we then would get: Desirable 50,000,000 But, Undesirable 1,000,000 Removed 500,000 Removed 500,000 Balance 49,500,000We now have 500,000 or a reduction of only 1% which should be rapidly replaced with or a reduction of 50% in this category, bringing the population back to a more normal state, where it should stay if conditions of normal good health prevail.
Bentonit Tedavisi Bentonit > Sayfa 24


















